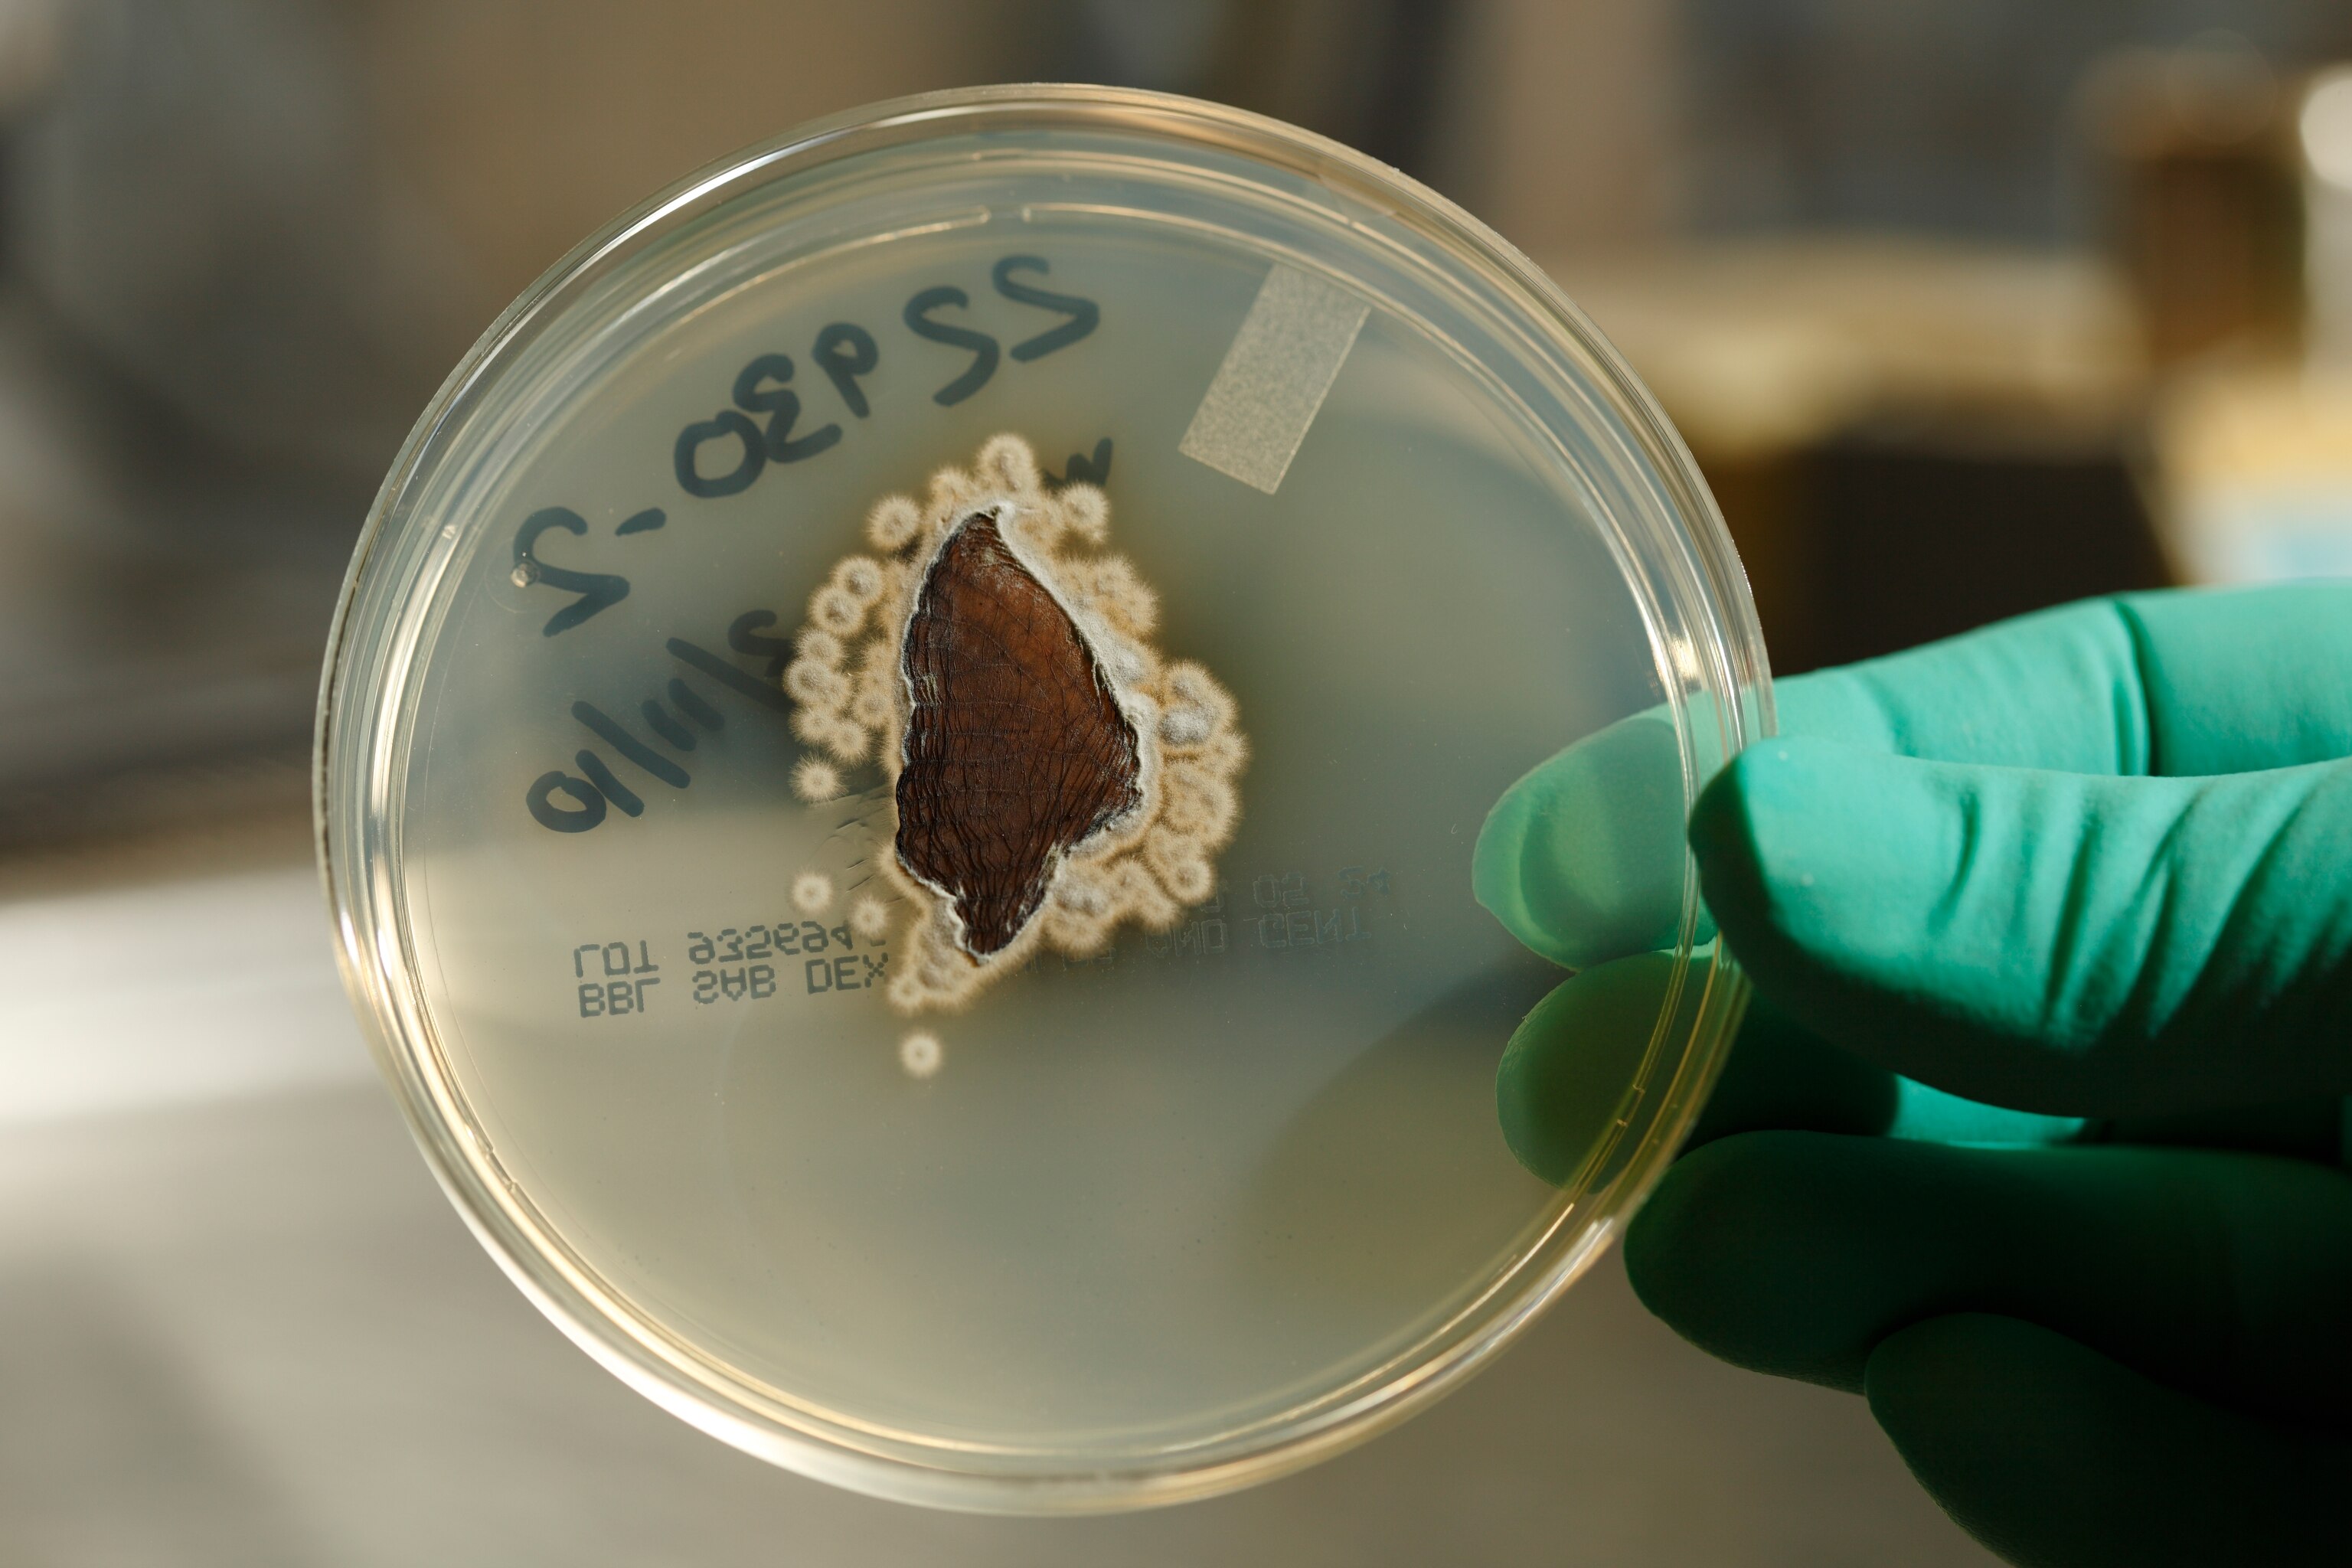

To save Yosemite’s bats, scientists need help finding them
A deadly fungus has killed millions of bats across North America over the past decade. To protect the bats in the park, biologists first need to document the many places they roost.
YOSEMITE NATIONAL PARK, CALIFORNIA — Shannon Joslin adjusts the beam of her headlamp and looks deep into one of the countless finger-size cracks that make Yosemite National Park a rock-climbing mecca. The granite seems to pour out of Yosemite Valley to the west on this crisp October morning, and beneath us is nothing but air and the gleaming ribbon of the Merced River a thousand feet below. As we descend the north face of a pillar known as the Rostrum, the wall is so overhanging that we periodically need to affix our ropes to the rock lest we end up dangling in space.
In addition to the standard climbing gear of ropes, rock protection, and belay devices, Joslin and field technician Sean Smith have measuring tapes, N-95 masks, cameras, endoscopes, and tripods attached to their harnesses. That’s because they’re here not just to climb: They’re checking on bats that had been found roosting on the Rostrum.
From the ground, Yosemite’s walls might seem barren, but they teem with creatures—everything from peregrine falcons to tree frogs to wood rats. Add to this list 17 species of bats, unsung heroes of the night, gobbling up mosquitoes, eliminating agricultural pests, and depositing fertilizer. Bat droppings—guano—provide nutrients for plants that attract insects, food in turn for birds (and bats) that make their nests on Yosemite’s cliffs.

Gabe Reyes, a biologist with the U.S. Geological Survey who studies bats in California, says the night-feeders provide “round the clock” pest control. And because bats can travel large distances, it’s possible that bats roosting in Yosemite sometimes fly to farms in the foothills of the Sierra Nevada to feed on insect pests.
Their importance is why there’s a pressing need for biologists who love to climb. During the past decade, white-nose syndrome—caused by a fungus called Pseudogymnoascus destructans (Pd, for short)—has killed more than five million bats in North America. Pd attacks bats’ skin while they hibernate, and the discomfort makes them more active, burning critical fat stores they need to survive the winter. Pd spread west from New York state and has been found on bats in four California counties since 2018.
California grows more than a third of the country’s vegetables and three-quarters of the fruits and nuts. If bats in the state were to face massive die-offs from white-nose syndrome, farmers would likely need to spend millions of dollars on pesticides to make up for the loss of services bats provide for free.
“It’s not if Pd comes to Yosemite, it’s when,” says Joslin, a former professional climber who is now nearing completion of a Ph.D. in the population genetics of endangered species at the University of California, Davis. When the pathogen does show up, she says she and Smith want to study how it spreads and affects bats in the park. But they can’t do that without knowing where the bats hibernate—that’s when they’re susceptible to the disease. So their first goal is to document as many roosts and wintering havens as possible (Learn why bats are the real superheroes of the animal world).
“If we don't have baseline metrics on how many bats are in any particular place, we don't know if their populations are decreasing or increasing,” Joslin says, so when Pd hits, they wouldn’t be able to assess its effects.
When they find a new roost, she says, they log it in a database by exact location; just this year, they’ve added 16. They’ll revisit each roost to see if the bats return year after year, how many use it, and whether it’s their base only in certain seasons. And importantly, to find out if the roost is a wintering home as well as a place for daily slumbers.
Next year, the team will place tiny data monitors (Joslin describes them as the size of four pennies stacked on top of each other) in the roosts to measure temperature and humidity, which will help determine whether the right conditions exist for Pd. And if white-nose syndrome does appear in Yosemite, they’ll climb to roosts to swab bats to test for the disease.
“Pd grows in a very narrow temperature range and also a very narrow humidity range,” she says, adding that “out east, those conditions are easy to find,” especially in caves. But in Yosemite, where the winters are drier and milder, they’re not sure if or how Pd would spread. Yosemite’s big walls host a range of microclimates that could make one side of the valley safer than others. Joslin has an inkling that Yosemite’s sunny south-facing cliffs could be inhospitable for Pd and serve as a refuge.
She says that finding the right conditions for hibernation is a “goldilocks situation” for bats. If it’s too cold, they’ll burn too much energy to maintain their body temperature. If it’s too hot, they won’t enter a deep torpor and will burn through fat stores faster, which could weaken their immune response to diseases. With bats dying from white-nose in similar environments in Washington state, the researchers are trying to learn as much as possible before it reaches Yosemite.

‘My brain sort of exploded’
The Yosemite bat project took root four years ago when Breezy Jackson, who was working as a field biologist for the park, attended a lecture about efforts to find bat roosts in the Northeast, where white-nose syndrome was decimating populations. The scientists explained how they’d used telemetry to track bats to a cliffside roost but couldn’t reach it to investigate because it was 20 feet off the ground.
“All of a sudden, my brain sort of exploded,” Jackson says, “because I realized that the cliff ecosystem landscape in Yosemite is incredibly vast, and it would be quite the project” to climb there looking for bats.
She teamed up with Yosemite’s climbing rangers, who specialize in patrolling and surveying the vertical wilderness, and in 2018 created Big Wall Bats with the goal of understanding the potential for white-nose syndrome in the park. When funding dried up during the COVID-19 pandemic, Jackson left the National Park Service to direct the Yosemite and Sequoia Field Stations for the University of California, Merced.
Now, Joslin and Smith are revitalizing the program, energized by new funding earlier this year from the Yosemite Conservancy. The pair brings a rare combination of qualities—the detail-obsessed nature of wildlife biologists and the gritty tenacity of climbers—Jackson says.
As climbers, they're used to sizing up rock walls for cracks they can fit their fingers into or knobs of granite they can balance their feet on. But now as they climb, they’re also scanning for piles of bat guano and openings in the rock that would make a good bat roost: ones that are small and down-facing, with enough clear space below to let emerging bats fall safely before their wings catch the air.
Yosemite Valley is home to thousands of acres of vertical granite, and it would take lifetimes for such a small team to survey it all for bats. In June, for example, the pair spent four days on the 3,000-foot wall of El Capitan, sleeping in portable ledges tethered to the wall as they scoured a route called Lurking Fear for roosts.
From the start, Jackson knew it would be crucial to enlist the help of recreational climbers in reporting any bat or guano sightings. “It's a frontier that we're really only able to access in modern times because of climbing becoming so popular and people having the skills to safely access these ecosystems,” she says. (Recreational climbers discovered the roost on the Rostrum Joslin and Smith set out to investigate that October morning.)
If you’re a climber in Yosemite and come across anything bat-related, be very careful not to disturb the bats, Joslin says, and submit the information to the Big Wall Bats email address, yose_bats@nps.gov. Joslin and Smith will schedule a climb to the site to gather more data. This year alone, climbers have alerted them to about 40 bat sightings around the park.
A conversation about risk
When I showed up to shadow the bat sleuths on the Rostrum, Joslin was wearing a homemade shirt with an x-ray of a bat claw printed on it: “My eyes have opened up to the magical world of bats,” she said.
Our day began with a conversation about risk—hazards such as falling rocks, difficulty communicating while we’re rappelling, and the ever-present necessity of being aware of one’s surroundings when dangling a thousand feet off the ground. They’d brought thick plastic material to help protect our ropes from sharp edges and compact radios so we could talk to each other once we began descending the Rostrum. We wore our masks to prevent spreading disease to bats.
After three hours working our way down to the roost, we were disappointed: not a bat to be seen. Finding an empty roost isn’t unexpected, Joslin said. They might have moved on to find better roosting conditions or to find a better launching place for nighttime foraging.
The day before, as a warm-up for the Rostrum, we’d hiked at dusk up a steep trail toward the west side of El Capitan to watch bats leave a roost for their night’s hunt. As I struggled to keep up, Joslin and Smith chatted casually as they used fixed ropes to pull themselves up and over the rock band that separated us from a small ledge where we marked time until dusk. We waited and waited, but no bats emerged. Then we trudged back down to listen to mastiff bats hunting in the meadow below.
One of only two of Yosemite’s species whose echolocation is audible to human ears, mastiff bats’ high-pitched squeaks speed up as they home in on prey—likely “big, juicy moths,” Joslin said. As we listened to the faint chirps above our heads, we watched the headlamps of climbers testing their night-climbing mettle on the massive cliff.
I asked Joslin how many bats live in Yosemite Valley. She laughed. “When you’re surrounded by 3,000-foot monoliths on either side,” she said, “it’s probably in the hundreds of bats in just in one crack, and how many cracks exist in these monoliths?” Her eyes swept over the valley. “It’s endless.”